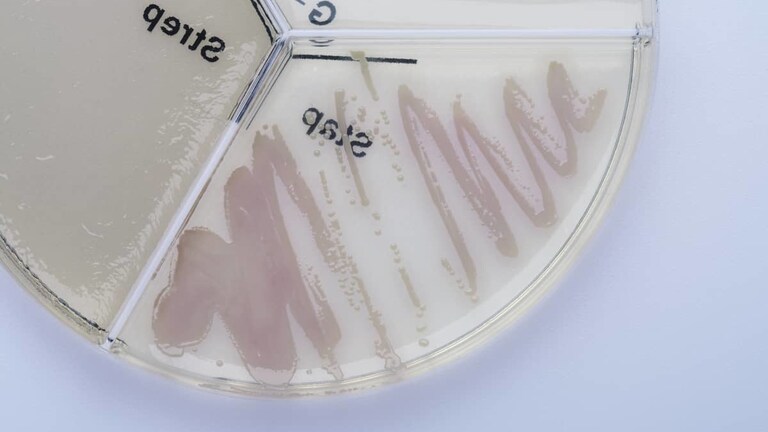
Staphylococcus chromogenes ClearMilk Test

Staphylococcus chromogenes is another bacterium from the Staphylococcus genus, which causes subclinical mastitis in dairy cows. In the Czech Republic, it is being diagnosed in more than 20% of cases of staphylococcal subclinical mastitis, the second after the predominant S. aureus. Veterinarians in some European countries (e. g. Belgium, the Netherlands, Denmark) state in their professional publications that up to 50% of staphylococcal mastitis other than S. aureus are caused by Staphylococcus chromogenes.
The interesting fact is that subclinical mastitis with higher count of cellular elements in milk caused by Staphylococcus chromogenes occur, according to the data in the literature from many countries all over the world, where the machine milking is being used. But the occurrence differs significantly among herds of dairy cows.
Professional article in English: https://doi.org/10.3168/jds.2020-18685